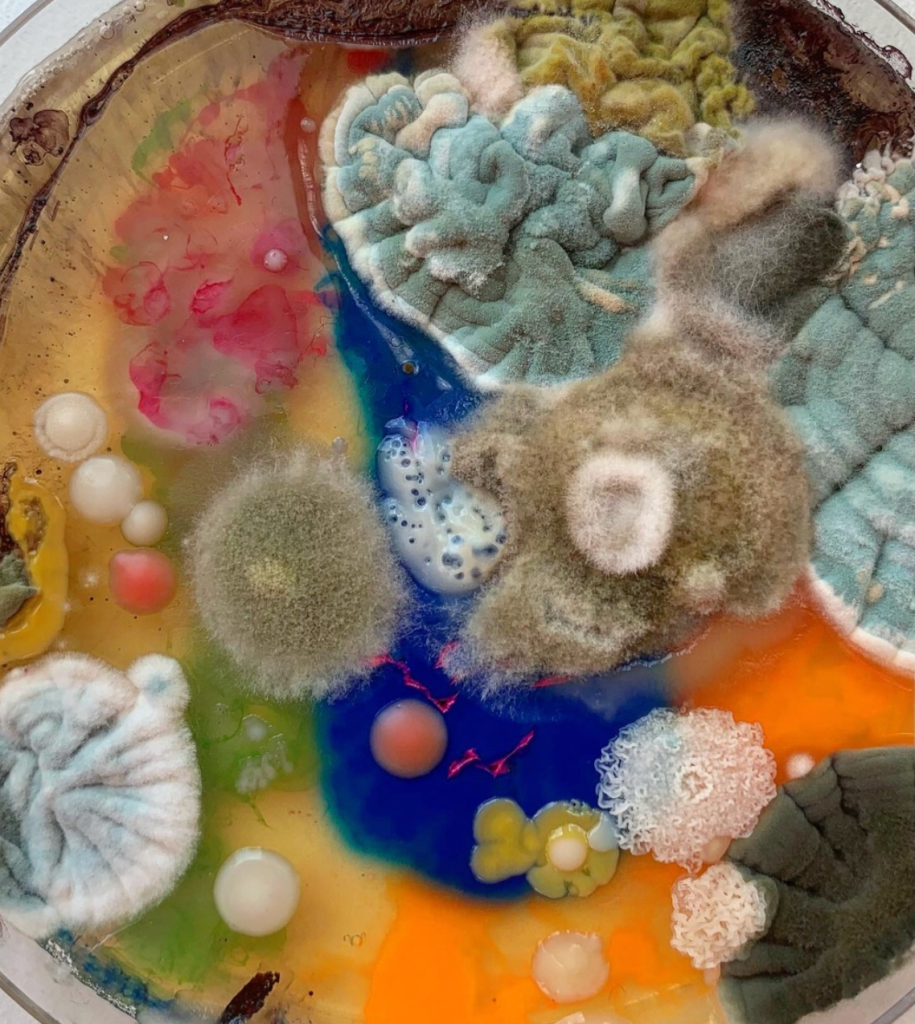

“Fungi represent one of the most diverse and abundant eukaryotes on earth. The interplay between mold exposure and the host immune system is still not fully elucidated. Literature research focusing on up-to-date publications is providing a heterogenous picture of evidence and opinions regarding the role of mold and mycotoxins in the development of immune diseases. While the induction of allergic immune responses by molds is generally acknowledged, other direct health effects like the toxic mold syndrome are controversially discussed. However, recent observations indicate a particular importance of mold/mycotoxin exposure in individuals with pre-existing dysregulation of the immune system, due to exacerbation of underlying pathophysiology including allergic and non-allergic chronic inflammatory diseases, autoimmune disorders, and even human immunodeficiency virus (HIV) disease progression. In this review, we focus on the impact of mycotoxins regarding their impact on disease progression in pre-existing immune dysregulation. This is complemented by experimental in vivo and in vitro findings to present cellular and molecular modes of action. Furthermore, we discuss hypothetical mechanisms of action, where evidence is missing since much remains to be discovered.”
More on Mold, Mycotoxins and a Dysregulated Immune System: A Combination of Concern? via International Journal of Molecular Sciences.
